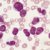
Моноциты в крови у ребенка: нормы и отклонения

Как выбрать и с какого возраста можно использовать ходунки для детей
Для развития детей во всем мире изобретается множество игрушек и приспособлений, призванных ускорить процесс адаптации маленького человека к окружающему его миру. Одним из самых популярных и распространенных устройств такого рода являются ходунки для малышей. Из этой статьи вы узнаете, что это такое, как ими пользоваться и стоит ли их приобрести.
Описание и назначение
Ходунками называется рама с прикрепленными к ней колесами и сиденьем, на которое садится малыш. С помощью этой конструкции ребенок отталкивается ногами от пола и развивает свои двигательные способности.
Дети осознают, что они могут самостоятельно передвигаться без помощи взрослых. Помимо физического развития, стоит отметить и психологический аспект: устройство отлично развлекает малыша — он получает удовольствие от нового способа познания мира.
С какого возраста можно использовать ходунки
Обычно считается, что после шести месяцев малышу пора начинать пользоваться ходунками. Это не совсем так, ведь каждый маленький организм развивается по-своему — кто-то с задержками, кто-то с опережением.
Правильно определить, с какого возраста использовать ходунки, можно будет, когда ребенок начнет сидеть прямо и подниматься в кроватке без посторонней помощи. Конструкция устройства такова, что вся нагрузка распределяется на позвоночник и тазовый пояс.
Виды
Все подобные конструкции для улучшения детской моторики различаются по внешнему виду, функциональности и возможности применения.
В зависимости от активности ребенка и особенностей его мировосприятия, родители могут выбирать следующие виды ходунков для детей:
Рассмотрим все перечисленные виды подробнее и попробуем разобраться, какие ходунки лучше для ребенка.

Классика
Классические ходунки представляют собой замкнутую конструкцию вокруг сиденья со свободно поворачивающимися колесами (обычно от 4 до 8). Такое устройство позволяет зафиксировать ребенка и предотвратить его падение.
В данном случае свобода и направление перемещения зависят лишь от любознательности малыша и отсутствия внешних преград.
Трансформеры
Наиболее многофункциональным устройством являются ходунки-трансформеры, представляющие собой разнообразный аттракцион для ребенка.
В зависимости от конструкции, трансформеры могут преобразовываться в каталку, качалку, мини-батут, обычные ходунки, столик для приема пищи или поверхность для попыток рисования.

Каталка
Достаточно свободная интерпретация — в данном случае дети могут передвигаться, толкая перед собой некое подобие машинки на колесах с высокой ручкой, за которую можно держаться.
Такая конструкция предназначена для тех, кто уже может самостоятельно шагать, даже если и не слишком уверенно.
Прыгунки
В принципе, это не совсем ходунки, как это и видно из названия. Конструкция прыгунков состоит из пружинящих лент, которые прикрепляются в удобном месте (дверной проем, между деревьями, столбиками или вбитыми кольями в саду).
На лентах могут располагаться различные элементы — от стилизованных «трусиков» до всевозможных бамперов в виде столешниц, микроавтомобилей и даже космических аппаратов.

Как правильно выбрать
Выбор ходунков для малышей, как по виду, так и по особенностям конструктивных элементов, является достаточно важным решением. Ребенок проведет много времени, познавая мир с помощью этого приспособления.
Здесь важно обратить внимание на все нюансы, которые в итоге могут оказаться серьезными и вовсе не мелочами.
При планировании покупки рассматриваются такие параметры и характеристики:
- конструкция изделия;
- возраст ребенка;
- основание ходунков;
- тип сиденья;
- колеса — количество и расположение;
- сопоставимость размеров;
- безопасность при использовании.
Тип конструкции
Помочь выбрать конструкцию для будущей покупки могут наблюдения родителей за поведением своего малыша. Более активные детки будут рады прыгункам.
Те, у кого наблюдаются частые изменения настроения — от веселья до капризности, — могут увлечься различными трансформерами. Любознательные исследователи окружающего мира с удовольствием повезут перед собой каталку.
А будущие мыслители уединятся в классическом варианте, рассматривая любые направления передвижения в пространстве.
Возраст
Для самых маленьких деток, которым уже можно пользоваться ходунками (приблизительно с полугода), стоит приобретать более простые и спокойные модели. При этом нужно учитывать степени защиты от травмирования — наличие всевозможных ограничителей, буферов, подушек безопасности.
С ростом малыша можно переходить к более мудреным конструкциям, где будет возможность чувствовать большую свободу и независимость.
Когда ребенок станет еще активнее и взрослее, ему можно доверить игры с «экстремальными» моделями.
Основание
Надежность и устойчивость приспособления зависит от прочности, формы и материала основания. Малыш может травмироваться из-за излишней легкости конструкции.
И наоборот, слишком сложная и массивная рама классических ходунков, или низ каталки, создадут лишние нагрузки при их перемещении.
Сиденье
Одним из наиболее важных элементов изделия является сиденье. Оно должно быть достаточно мягким, глубоким, с системой фиксации. Материал сиденья предпочтителен тканевый со вставками из впитывающих, мягких и амортизирующих материалов (например, поролона).
Стоит обратить внимание на спинку ходунков — чем она выше и жестче, тем удобнее она будет для малыша. Такая спинка минимизирует нагрузки на позвоночник.

Колесики
Количество колес в разных моделях варьируется — обычно от четырех до восьми. Это в значительной степени влияет на устойчивость устройства и, как следствие, на безопасность.
Сдвоенные и свободно вращающиеся основные колесики располагаются в углах или диаметрально противоположно по периметру основания, а вспомогательные — в центрах сторон или через одинаковые промежутки.
Если колеса в выбираемой модели съемные — это будет дополнительным плюсом, так как их можно легко демонтировать и очистить.
Размеры
Габариты изделия должны соответствовать антропометрическим данным малыша — в любом случае на приспособлении обязательны регулировочные пряжки и карабины, чтобы подогнать его под рост и полноту.
Также нужно учитывать и размеры помещения или площадки, где ребенок будет познавать мир с помощью ходунков. Не стоит приобретать излишне громоздкие конструкции, если жилищные условия не соответствуют свободе перемещения.
Безопасность
Этому параметру уделяется особое внимание, ведь речь идет о здоровье детей.
Тут можно выделить такие аспекты безопасности:
- правильная посадка и настройка;
- временные рамки;
- обеспечение свободы пространства;
- психологические факторы.
Использование ходунков приносит радость ребенку, но может серьезно ухудшить его физическое здоровье. При посадке на сиденье необходимо проследить, что его высота отрегулирована достаточно для того, чтобы ножка маленького «наездника» полностью доставала до поверхности отталкивания.
В противном случае существует высокая вероятность образования плоскостопия. Можно надеть на ножки малыша обувь с твердой подошвой.
Неудобное положение тела провоцирует усталость, из-за чего дети стараются менять позу, «скрючиваются», ищут другую, более удобную для себя позицию. Такие действия могут вызвать заболевания позвоночника (сколиоз, лордоз).
Время, которое проводится детьми в ходунках, должно быть строго дозировано. Для начала — минут 15-30, в зависимости от внешних проявлений усталости.
При этом необходимо всегда наблюдать за поведением ребенка, чтобы не допустить наклонов в стороны, капризов и прочих проявлений неудовольствия.
Окружающее пространство помещения должно быть избавлено от таких предметов мебели и интерьера, которые могут нанести ребенку травму или вызвать его раздражение, создавая препятствия при перемещении.
В зоне передвижения не должно быть объектов с острыми краями или гранями, а также доступа к лестницам, опасным механизмам, резким преградам.
Конструкция ходунков должна обеспечивать собственную защиту в виде буферов, ремней и поясов безопасности.
При возникновении ситуаций, которые могут испугать ребенка (наезд на препятствие), «водитель» ходунков может неправильно отреагировать, поэтому ему будет нужна помощь взрослого человека, чтобы успокоить, исправить ситуацию и позволить продолжать движение.
Таким образом, необходимо постоянно присматривать за малышом — вне зависимости, в ходунках он или нет.
Противопоказания
Малыш может быть попросту физически не готов к этому приспособлению. В таком случае, знакомство стоит отложить до лучших времен.
Детей с какими-либо нарушениями опорно-двигательного аппарата, вроде начальных признаков рахита, повышенного или пониженного тонуса ног, раздражением или воспалением кожных покровов в местах соприкосновения с поверхностями ходунков, не нужно допускать к данному устройству.
Когда малыш оказался не готов к такой игрушке на психологическом уровне, его не нужно уговаривать и заставлять.
Скорее всего, необходимо переждать такое настроение или состояние, после чего изменить подход, пояснить и показать, что устройство не несет в себе ничего плохого для ребенка и его уже можно сажать в ходунки.
Плюсы и минусы
Если рассматривать использование устройства с точки зрения развития способности ходить, то здесь этот аппарат больше вредит, чем приносит пользу.
Ребенок, привыкая искать точки опоры для тела при движении во всем, чем угодно, кроме ступней ног, может осознать, что его устраивает и такой способ передвижения. Именно поэтому не стоит увлекаться длительным использованием ходунков. Поиск опоры руками приводит к естественному нахождению таковой на раме устройства. В итоге у детей не развивается чувство равновесия, и при окончании пользования ходунками они могут часто падать.
Инстинкт «правильного» падения, который вовремя не развит, может привести к травмированию в простых ситуациях.
Плюсом применения ходунков является ускоренное развитие ребенка, так как с помощью устройства он становится мобильнее и менее хаотичен в своих перемещениях. Это позволяет повысить его настроение и, в какой-то мере, даже самооценку.

Полезные советы
Чтобы сделать правильный выбор, нужно учесть некоторые детали:
- у продавца изделия нужно требовать инструкцию на детские ходунки и сертификаты с указанием страны-производителя и всех ограничений (вес, возраст, условия применения и т. п.), а также подтверждением качества;
- детали крепежа должны быть преимущественно стальные;
- столешницу следует выбирать такой ширины, чтобы руки ребенка не доставали до ее края;
- сиденье перед покупкой можно испытать, нажав на него несколько раз, проверив на упругость, мягкость и пружинистость;
- на колесах должен быть предусмотрен тормоз, который не позволит конструкции самостоятельно покатиться;
- вертикальная планка для размещения игрушек непрактична — она закрывает малышу обзор;
- прямоугольная конструкция ходунков значительно устойчивее круглой.
Учитывая все разнообразие советов и мнений по поводу необходимости покупки ходунков, родители должны самостоятельно определить, когда их стоит приобрести.
Если есть какие-либо сомнения, нужно проконсультироваться с педиатром, который подскажет, как правильно выбрать ходунки для ребенка и когда его можно в них сажать.
Приложив немного усилий, вы сможете не только помочь вашему малышу побыстрее начать ходить, но и порадовать его новой игрушкой.

Наталья Блинова